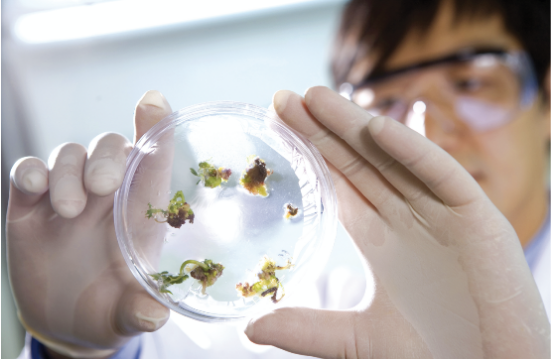

315后,正官庄品质先行
俗话说,民以食为天,食品安全问题直接关乎人们切身利益,也成为每年315晚会关注的重点。今年315晚会聚焦食品生产安全的“不卫生的辣条”、涉及营销虚假宣传的“化妆的土鸡蛋”等乱象,再次让“品质”成为消费者热议的话题。

作为一个特殊的食品种类,养生保健食品同样受到人们的关注。鱼龙混杂的市场现状,使得不少商家盯上了这个年轻的食品市场,特别是像人参、高丽参等细贵料。在此前的315晚会中,就曾曝出部分商家利用加糖的红参冒充高丽参进行销售。小编建议,购买人参、高丽参等养生保健食品,还是尽量前往正规渠道购买,或选择安全、质量有保障的大品牌。
正官庄是韩国人参公社旗下的代表品牌,前身是专门掌管高丽参制造及输出的官方机构。120年以来,正官庄始终坚持“品质先行”,生产品质可靠的系列参制品,受到各国消费者的信赖!

好品质,源自好的原料栽培
自古以来,人参便被视为“物宝天华”。不仅因其产量稀少,更因其生长环境的严苛,需要长时间的人为照料。作为多年生草本植物,人参播种后第2年就要移栽,第4年后需特别预防病虫害,艰难成长到第6年才算充分成熟。
由于人参会吸尽土壤中的有机物精华,收获人参后的参田必须养地10年,再经过2年的土地翻整后才能继续种植。因此,一根6年根高丽参需经历18年的悉心守候。正官庄系列产品,正是用这6年根高丽参精心制造的。

好品质,源自好的生产管理
6年根高丽参固然出色,但是高昂的人力成本和时间成本宛如一张“逐客令”。为了让每一株高丽参健康茁壮地生长,正官庄主动分担与减少参农的压力:与优质种植区域的参农签订种植收购协议,并向农户给予技术支持。
另外,从参苗落地到最终收成,除了6年的漫长等待外,还必须经过5次检测,包括种植前土壤检测、第二年对幼苗检测、种植第五年检测、种植第六年初检测和第六年收获前检测。检测标准符合KOLAS国际公认检测认证,每次的检测项目涵盖农药残留以及重金属成分多达290余种。
好品质,源自好的制作工艺
作为曾经的宫廷贡品,正官庄高丽参有着一套完整的生产流程,是工匠精神的结晶。120年来,正官庄一直传承工匠精神,从未改变。虽然如今有了现代化的制作工艺,但在实际生产过程中还保留着很多手工操作,以保证高丽参的品质优良。特别是在高丽参的内部组织筛选过程中,每支高丽参都是由具有20年以上经验的高丽参鉴定师人手逐一鉴定,为每一根高丽参的品质把关。

回顾315晚会,“品质”问题再次给所有健康企业敲响了警钟。正官庄在120年的品牌发展历程中,始终怀着高度责任心,以人类健康幸福为已任,把“品质”作为对消费者的重要承诺,为我们带来了放心的高丽参。品质养生,品质生活,就从正官庄开始!
下一篇:苏宁易购智慧零售驱动场景零售全面爆发
返回首页